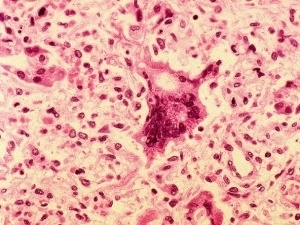
Clula infectada pelo vrus do sarampo

Três ocorrências foram no Pará e outras duas no Rio Grande do Sul
Brasil confirma cinco casos de sarampo em 2010
Após quatro anos sem qualquer registro de sarampo no Brasil, cinco casos da doença foram confirmados em agosto no país. Todos eles, no entanto, são importados – os pacientes se infectaram após viajarem para o exterior.
Nesta semana, o governo do Rio Grande do Sul confirmou a doença em duas crianças, de 11 e 12 anos, de uma mesma família. Elas viajaram para Buenos Aires entre os dias 22 e 28 de julho e voltaram infectadas com o vírus. Nesse período, foram confirmados na capital da Argentina três casos de sarampo em pessoas que viajaram recentemente à África do Sul, segundo o Ministério da Saúde do país vizinho.
Já os outros três casos no país foram confirmados em Belém, no Pará, no início de agosto. Nenhum dos pacientes brasileiros tinha se vacinado contra o sarampo.
O Brasil interrompeu em 2000 a circulação do vírus autóctone da doença (contraído dentro do próprio país). Desde então, outras ocorrências foram confirmadas, mas todas elas importadas. O último evento foi em 2006, quando 57 casos foram notificados na Bahia.
O sarampo é causado por um vírus que se propaga no ar. É uma doença aguda, altamente contagiosa, transmitida de pessoa para pessoa por meio das secreções expelidas ao tossir, espirrar, falar ou mesmo respirar. No início, o paciente apresenta febre, tosse, catarro, conjuntivite e fotofobia (intolerância à luz). Depois esses sintomas são acentuados, com indisposição do paciente e aparecimento de manchas avermelhadas na pele. A vacina é o meio mais eficaz de prevenção e a dose está disponível nos postos de saúde para crianças a partir de 12 meses de idade.
Governo investiga mais casos no RS
Após o registro dos dois casos no Rio Grande do Sul, o Ministério da Saúde investiga a possibilidade de novas infecções no Estado, sobretudo na capital, Porto Alegre. De acordo com a pasta, os exames realizados nas crianças, apesar de ter resultado positivo, são considerados preliminares, e as amostras colhidas foram enviadas para a Fiocruz (Fundação Oswaldo Cruz), no Rio de Janeiro. O resultado final está previsto para a próxima semana.
Uma das crianças foi internada e liberada. A outra continua hospitalizada na UTI, mas sem uso de respirador. O quadro é de boa evolução, de acordo com informações da Vigilância em Saúde do Estado.
Além de buscar novos casos suspeitos, as autoridades locais de saúde vão intensificar a vacinação na faixa etária de 1 a 39 anos. O centro de vigilância alerta para que quem tiver viajado ao exterior ou ao Pará, ou apresente os sintomas da doença, procure imediatamente os serviços de saúde.
MS emite nota esclarecendo sobre casos de sarampo no Brasil
Esclarecimento sobre casos recentes de sarampo
· Em virtude das recentes notícias sobre os casos de sarampo no país, o Ministério da Saúde volta a afirmar que a doença continua eliminada do território nacional. Ou seja, não há circulação do vírus internamente.
· O Brasil interrompeu a circulação autóctone do sarampo em 2000. Todos os casos que têm sido registrados nesses últimos dez anos são importados, como ocorre em outros países das Américas que já eliminaram a doença, como Estados Unidos e Canadá.
· Isso vale também para os recentes casos investigados, cujas evidências apontam que são pacientes infectados fora do país ou contaminados por estrangeiros que vieram ao Brasil.
· A presença de casos importados é esperada pela vigilância em saúde, mesmo após a eliminação do vírus no Brasil, devido ao grande fluxo de pessoas que vêm de países onde a doença ainda existe, como alguns países da Europa, Ásia e África.
· Foi o que ocorreu no Estado do Pará. No início de agosto deste ano, foram confirmados três casos importados de sarampo no Pará, pertencentes ao mesmo núcleo familiar. Os três irmãos não foram vacinados contra a doença. Segundo análise genética, o vírus é similar aos dos surtos registrados na Inglaterra, França, Itália e Holanda.
· No Rio Grande do Sul, dois irmãos, de 11 e 12 anos, apresentaram sintomas de sarampo. Eles estiveram com a família em Buenos Aires, de 22 a 28 de julho. Nesse período, foram confirmados na capital da Argentina três casos de sarampo, em pessoas que relataram viagem recente à África do Sul, segundo o Ministério da Saúde do país vizinho. De acordo com a família, os irmãos não foram vacinados por serem alérgicos a ovo.
· Portanto são casos isolados, importados, que foram imediatamente detectados pela vigilância em saúde brasileira.
· Como sempre ocorre na notificação dos casos de sarampo, o Ministério da Saúde reforçou as seguintes orientações:
§ Vigilância para identificação de ocorrência de novos casos suspeitos;
§ Notificação imediata, em até 24 horas, à Secretaria Municipal de Saúde;
§ Coleta de sangue e amostras para identificação viral;
§ Busca ativa de casos suspeitos não notificados nas unidades de saúde públicas e privadas (hospitais, unidades básicas, laboratórios, clínicas etc.);
§ Avaliação de cobertura vacinal.
· Essa recomendação tem sido reforçada pelas secretarias de saúde estaduais e locais, como nota divulgada nesta sexta-feira pela Secretaria Estadual de Saúde da Bahia, visando a detecção de casos que tenham sintomas compatíveis com a doença e imediata investigação. Esta conduta é rotina da vigilância epidemiológica e tem permitido a exclusão de casos com quadro semelhante, como dengue, herpes e outras infecções.
· À exceção do Pará e Rio Grande do Sul não há nenhum outro Estado que esteja com registro atual de caso suspeito de sarampo, considerando a presença de sintomas e sorologia compatíveis.
· A identificação dos casos recentes demonstra que a vigilância epidemiológica tem mantido uma elevada sensibilidade para detecção de casos importados.
· A vacinação contra a doença faz parte do calendário de rotina da criança, com cobertura vacinal acima de 99%, o que assegura uma proteção contra a reintrodução da doença no país.
· Além disso, em 2008, 67,9 milhões de crianças, jovens e adultos foram vacinados contra a doença durante a Mobilização Nacional para a Eliminação da Rubéola e da Síndrome da Rubéola Congênita (SRC), já que a vacina utilizada no Brasil protege também contra sarampo.
· O Ministério da Saúde reitera que todas essas medidas são de rotina, adotadas por todos os países que ja alcançaram a eliminação e visa assegurar sua manutenção.

Comentários